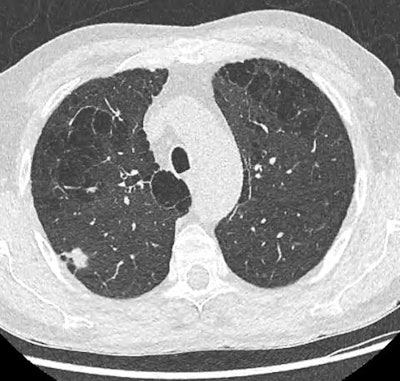
Low-dose injection-free thoracic CT scan of a 68-year-old man that was performed as part of the screening program (Prevalung study). After the workup, the patient was operated on, revealing a 14 mm adenocarcinoma classified pT1bN0M0. He is now under simple surveillance. Courtesy of Dr. Caroline Caramella and SFR and SIT.

A novel lung cancer screening examination has been developed in France. This examination and issues associated with rolling out population-based lung cancer screening have prompted intense discussion as the first pilot studies are initiated.
After years of hesitation, France's national Health Authority (Haute Autorité de Santé, HAS) decided in February 2022 to launch pilot programs for lung cancer screening using low-dose thoracic CT. This is not yet a population-based screening program as is the case for breast cancer, for example, but it is a very important step, according to thoracic experts.
The new exam will be launched during the next Journées Francophones de Radiologie (JFR 2023), delegates heard at the dedicated "Lung cancer screening, state of the art" session held at JFR 2022 on 9 October.
Unanswered questions
The majority of prospective randomized studies (NLST, NELSON, MILD, LUSI) have shown a reduction in specific mortality in screened subjects versus those not screened. The efficacy of screening by CT scan can therefore be taken for granted. However, transposing the protocols of controlled trials to a large population does not guarantee the same results.
Certain methodological questions remain unresolved -- for example, the precise definition of the target population (i.e., the population for which the benefit/risk ratio of screening is maximal), the duration and optimal rhythm of screening, the problem of overdiagnosis (i.e., a cancerous nodule which, if left untreated, would not alter the life expectancy of the patient), or the role of artificial intelligence (AI) software in assisting in the detection and characterization of nodules.
Population-based lung cancer screening also raises important organizational issues: How should at-risk subjects be recruited? How can the subjects' adherence to the screening program be ensured? What care pathway should be put in place? How can inequalities in access to screening be reduced? How should the medico-economic impact of screening be evaluated?
There are many pitfalls, and the experience of other organized screening programs (breast, colorectal, cervical) will undoubtedly be valuable.
France's national cancer institute (Institut National de Cancer, INCa) has begun to solicit lung cancer screening stakeholders (radiologists, pulmonologists, surgeons, tobaccologists, general practitioners, regional screening coordination centers, patient representatives) in order to structure this organization, particularly through pilot programs that will meet precise specifications.
Implications for imaging professionals
First of all, radiologists must be aware of their responsibility in an undertaking that could save 5,000 lives each year. As early diagnosis is based solely on low-dose thoracic CT, radiologists are on the front line and have a duty to train in screening. The SFR and the Thoracic Imaging Society (Société d'Imagerie Thoracique, SIT) have set up a teaching program open to all radiologists wishing to be trained in the interpretation of screening scans.
This program is available on the SFR e-boutique and combines e-learning courses and face-to-face workshops that allow training on numerous cases in real situations involving the handling of detection software and nodule volumetry.
In 2023, an exam will be organized during the JFR to validate this training and to deliver a screening certification. Additionally, SIT will publish the most recent recommendations on the performance and interpretation of screening scans in the near future. Finally, the SFR and SIT will also have a role to play in the regional evaluation of available thoracic imaging services, in the quality control of CT examinations, and in the promotion of research projects, the most advanced being the CASCADE study, which targets women who smoke or who have smoked.
Editor's note: This is an edited version of a translation of an article published in French online by the SFR in their newsletter, SFR Actu'. Translation by Frances Rylands-Monk. To read the original French version, go to the JFR website.
Dr. Caroline Caramella is a radiologist at Hôpital Marie-Lannelongue, Le Plessis-Robinson, île-de-France. Prof. Mathieu Lederlin is a radiologist at Hôpital Pontchaillou, CHU Rennes, France.